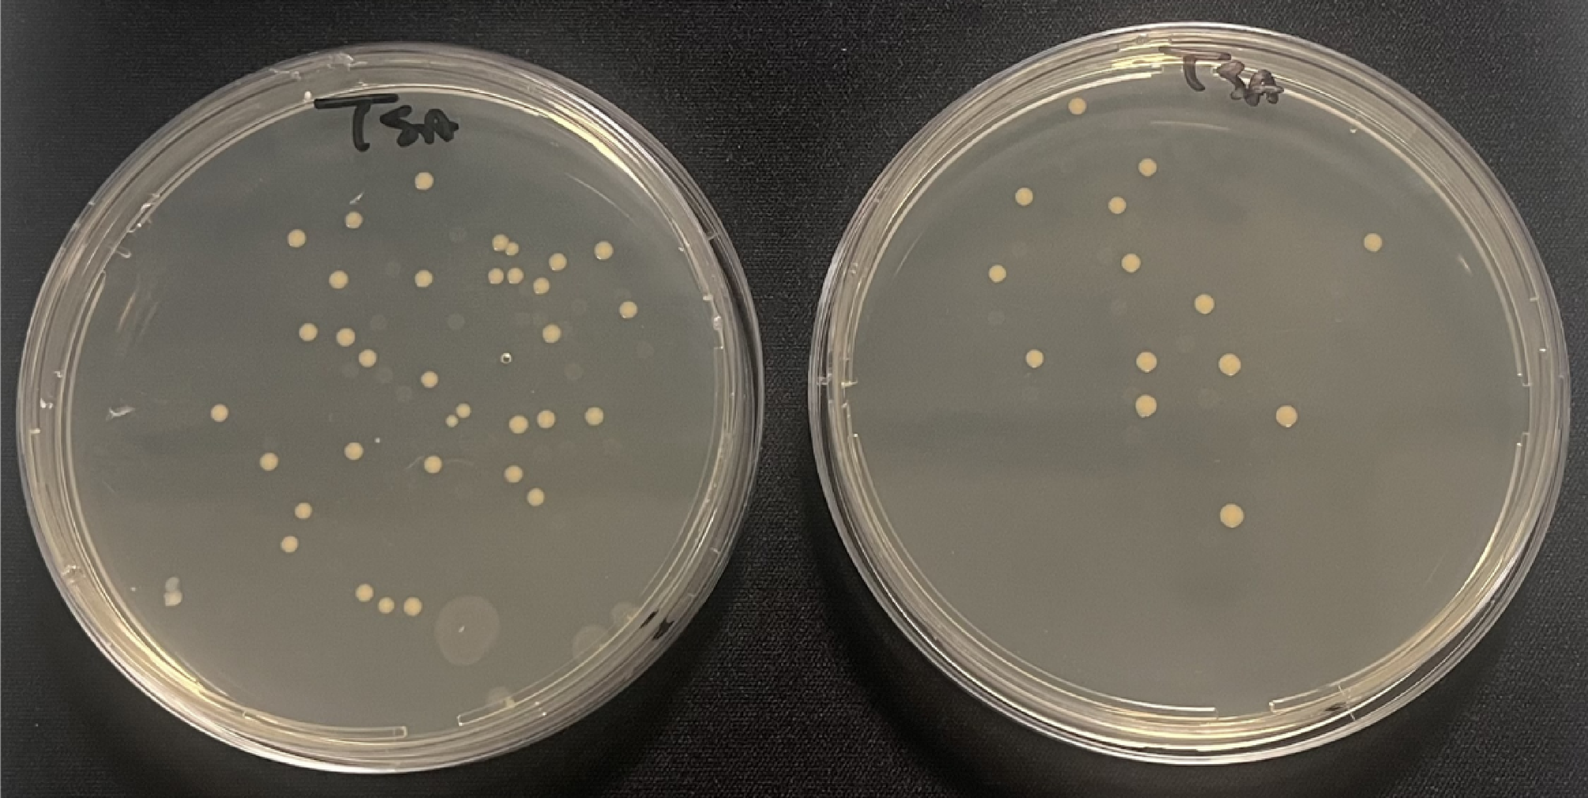
Fig. 3

Fig. 3
From: Hemoperfusion with Seraph-100 in septic patients removes pathogens and improves clinical outcomes
Representative pictures of a blood sample seeded in TSA culture medium plates before (left) and after (right) Seraph hemoperfusion session in which is well visible the Staphilococcus aureus growth. The reduction of the bacterial load is clearly visible from the reduction of the colony-forming units (CFU).
